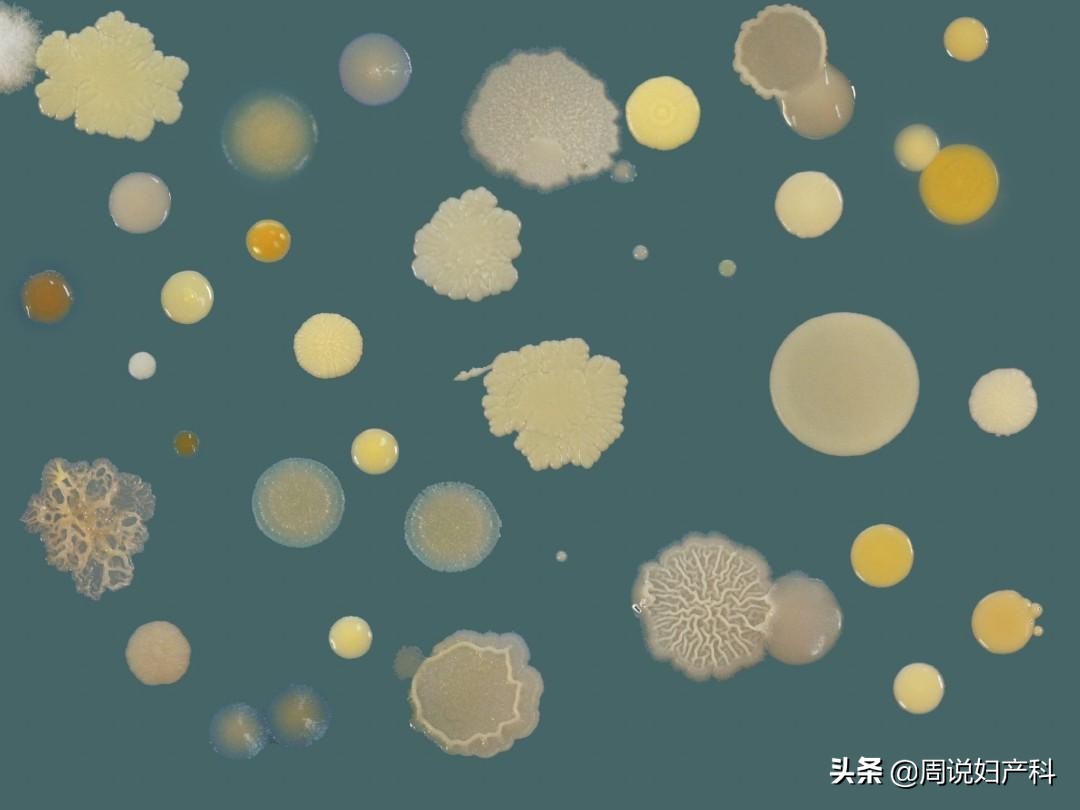
下面总是痒？也许是这个“好习惯”在作怪

本文为头条号“周说妇产科”所作,旨在通过文章分享女性健康与科学孕育的科普知识,希望能给大家一些帮助。
这一篇文章我们来看看女性朋友的生活习惯对健康的影响到底有多大!

“我天天用清洗液,怎么下面还会发痒?”
你有没有想过,天天使用的清洗液其实才是罪魁祸首?
“洗洗更健康”这句广告语可谓深入人心。
清洁除菌这还有错?不少小姐姐不管有病没病都选择入坑。
买买买洗洗洗,然鹅却洗出了毛病!

01 “*处私**的微生态环境”
女孩子因为特殊生理特性,很容易染上妇科疾病。所以,*处私**健康十分重要。
但不恰当的护理方式反而会引发很多的女性疾病。
女性的*处私**内部并不是绝对无菌的环境。
其中寄生着50多种微生物,如乳杆菌、双歧杆菌、拟杆菌等。
这些微生物之间相互制约、相互作用,有层次、有秩序地定植于*处私**内部黏膜上皮。
它们共同形成了一层生物屏障,维持着*处私**的微生态平衡。
在这些菌群中,以乳杆菌为优势菌,可以通过产生乳酸。
以维持*处私**的微酸性环境,抑制其他细菌生长。
然而,这种平衡状态易受机体激素水平变化、免疫状态、药物、感染等体内外各种因素的影响。
当这种平衡被打破,就会导致致病微生物过度繁殖,从而发生阴道感染性疾病。

02 “洗洗更健康?”
很多女孩子迷信“洗洗更健康”,每天用*处私**清洗液清洗*处私**。
其实,对清洗液的盲目迷信和误用,是现在很多女性感染阴道炎的原因。

乳酸杆菌在正常女性阴道内占比95%。
正因乳酸杆菌的大量存在,健康女性阴道pH值保持于3.80~4.44。
然而,目前市面上流通的*处私**洗剂多偏碱性,频繁地使用会破坏*处私**内的微生态平衡。
使乳杆菌数量减少,阴道内pH值增高,免疫系统的防御能力下降,从而导致了其他病原菌的迅速增长。
从成分上看,洗液基本分为两类。
一类是以植物提取物为主的护理液,没有治疗作用。
一类是以中草药或消毒液为主,有一定治疗效果。

许多洗液当中还会有一些香味剂之类的添加成分,会刺激皮肤黏膜。
长期使用会使之变得脆弱、敏感,增加炎症几率。
03 “*处私**护理的正确做法”
关于*处私**的护理,正确做法就是,平时没有不舒服的时候,温水清洗外阴就OK了。
但特殊情况也需特殊处理:
1. 大姨妈来临
勤换卫生巾,白天每2~4小时更换一次。
可以用纯水湿巾清理*处私**血渍,也可以温水清洗,但最好不要洗冷水浴,不要坐浴。

2. 夫妻生活前后双方都记得要清洗*处私**。
此外,尽量选择宽松舒适的纯棉*裤内**并勤换洗;非经期不要垫护垫。
注意营养,加强锻炼,提高身体素质等也是*处私**护理值得注意的事项。
3. 尽量避免使用*处私**洗液
健康状态下,每天清洗不宜超过2次,且最好用温清水。
清洗时需要注意清洗顺序,避免细菌进入尿道口。擦拭用毛巾不能与其他毛巾混用。
4. 养成良好的生活习惯
日常生活中应做到饮食有节、起居有常。不要过食辛辣、甘甜食品。

另外,要多食新鲜蔬菜、水果,多饮水,避免熬夜和过度劳累。
促进免疫系统的正常运行,有良好的抵抗力才能减少病毒侵害。
当然,如果已经出现*处私**瘙痒,千万不能默默忍着!
一忍再忍不仅会影响正常生活,还可能会酿成更严重的后果!尽早去看医生才是正确的选择!